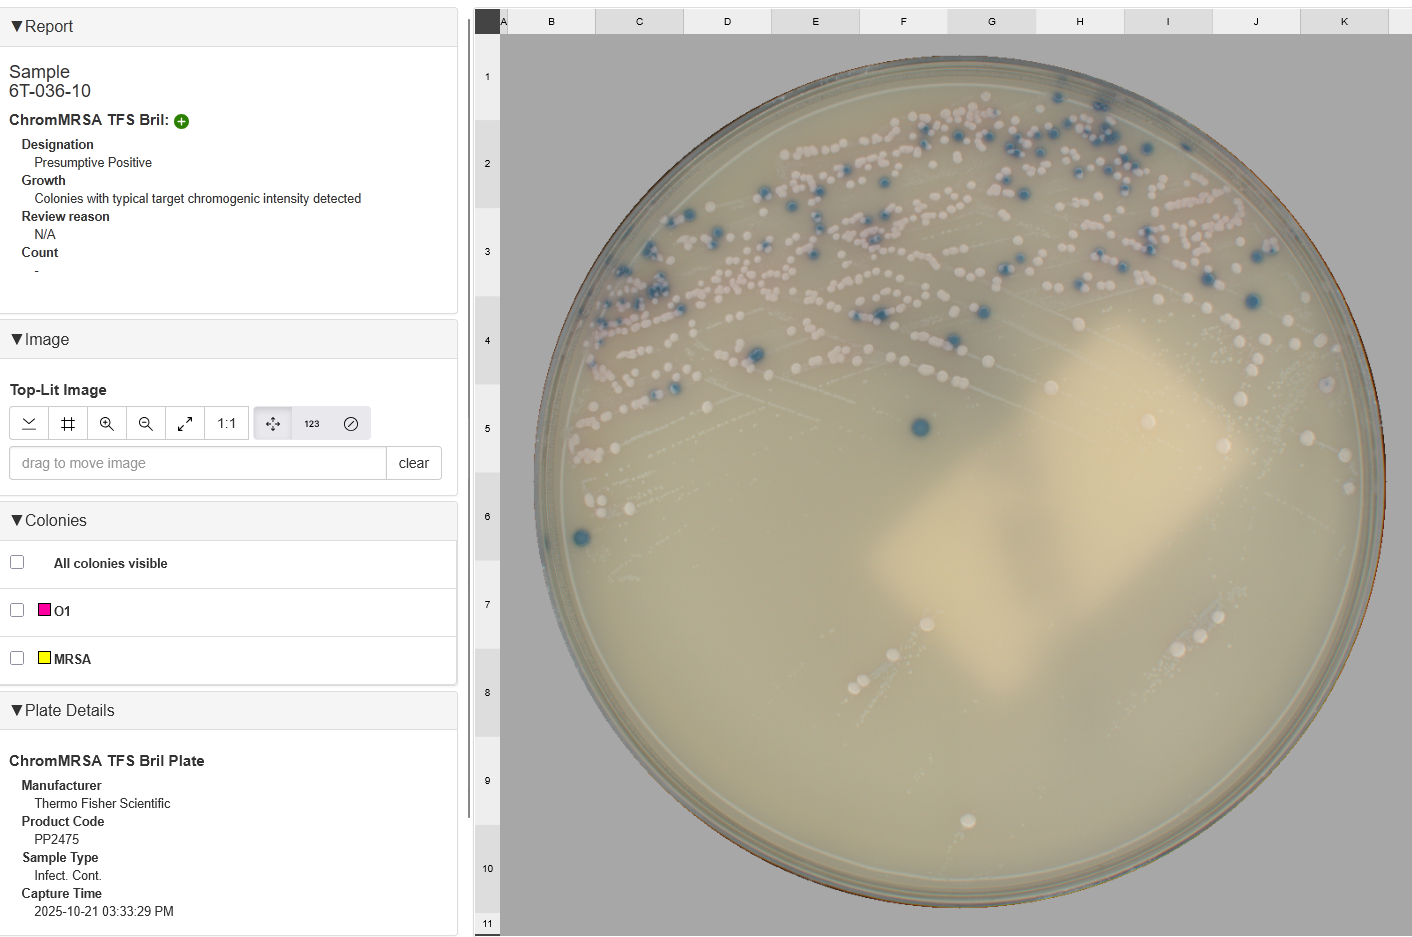

The APAS Clinical Analysis Modules contain the artificial intelligence algorithms that work with APAS Independence to enable digital microbiology culture plate reading. Each module is designed with the microbiology workflow in mind to
APAS Independence Clinical Analysis Modules are AI-enabled software that deliver the intelligent image analysis you need for accurate and efficient clinical microbiology automation.
Blood agar
MacConkey agar
Chromogenic agar
Bi-plates
Available
Chromogenic agar
Available
Mueller Hinton Agar
Disc Diffusion Testing
Available
VRE Analysis Module (RUO)*
Chromogenic agar
Available for evaluation